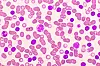

LEUKEMI: Kronisk lymfatisk leukemi (KLL) er den vanligste formen for leukemi hos voksne. I en ny studie har KLL-pasienter hatt god effekt av tidsbegrenset behandling med tabletter.
Illustrasjonsfoto: NTB/Shutterstock
Studie: Positive resultater av tablettbehandling hos leukemipasienter
Tidsbegrenset tablettbehandling med akalabrutinib og venetoklaks ga forbedring i progresjonsfri overlevelse hos pasienter med kronisk lymfatisk leukemi (KLL). – Interessant og viktig studie, ifølge overlege Emadoldin Feyzi ved St. Olavs hospital.
DM Pluss for helsepersonell
0 kr
Gratis for helsepersonell ved å oppgi HPR-nummer.
Registrer deg
DM Pluss
49 kr
for de første 30 dagene, deretter 417 kr (eks. MVA) per måned. Ett års bindingstid. Oppsigelse mulig i prøveperiode. Betal via kort og Vipps.
Registrer deg
Bedriftsabonnement
Ta kontakt med oss så skreddersyr vi løsning for deg og din bedrift.
Les mer